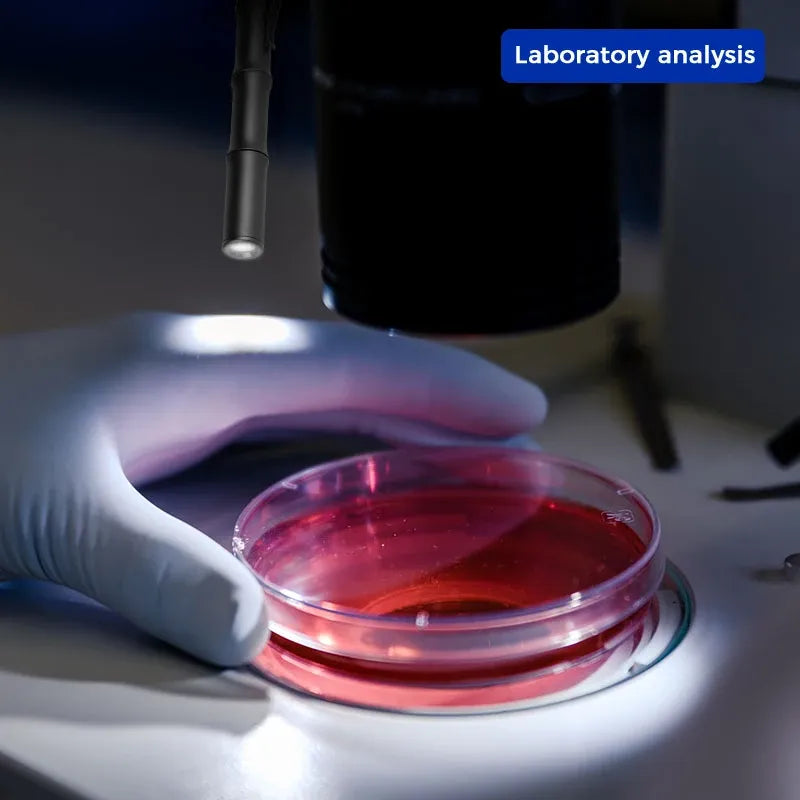
Brinyte PL01 Pocket Penlight for Proximity Illuminated

Brinyte
PL01 Pocket Pen Flashlight—Brinyte
We will ship your order within 1–3 business days after it is placed.
Free shipping is available for orders over $49.
For more details, please refer to our shipping policy.
If you have any questions, feel free to contact us via email at service@brinyte.com. We guarantee a response within 24 hours.
Get after-sale service directly from Brinyte official.
If you have any questions or need assistance, feel free to contact us at service@brinyte.com.
Recommendation from Mr Carson
Brinyte PL01, the ultimate companion for all your close-range tasks. From camping and reading to home repairs and inspections, this compact flashlight shines with its exceptional performance. With advanced LED technology, it delivers a powerful and focused beam, ensuring precision and clarity in any situation. Its rugged design withstands the toughest conditions, while its versatility allows for adjustable brightness levels. Trust the Brinyte PL01 to illuminate your path and conquer any task with ease. Upgrade your lighting game today and experience the superior advantage of the Brinyte PL01.
Brinyte PL01 Pocket Penlight Highlights
1.High /Low Light intensity and Mini appearance, portable and adaptable to multiple environments;
2.The A6061-T6 material and its artful oxidation process embody refined elegance and instill a profound sense of pride. From its tactile allure to its captivating aesthetics, every aspect exudes exquisite craftsmanship;
3.The integration of the bamboo knot design, inspired by Chinese elements, bestows upon it a unique blend of rigidity and flexibility. With its captivating style, it stands out as a true masterpiece.








Parameters
| LED | HF-2525*1 |
| Modes | High/Low White Light |
| Compatibility | 2*AAA |
| Max Output | 165+ LMS |
| Max Runtime | 920 mins |
| Beam Distance | 60+ m |
| Impact Resistance | 1.5 m |
| Waterproof | IP66 |
| Peak Beam Intenity | 880+cd |
| Material | A6061-T6 |
| Craft | Ordinary Oxidation |
Can be used for Penlight Flashlight, Illumination Portable Lighting, EDC (Everyday Carry),
Pocket Light, LED Light, Outdoor Gear, Emergency Light, Compact Light, Utility Light, Work Light, Inspection Light and Medical Light...
Package
| Quantity | Accessory |
| 1 | PL01 Tactical Pen Light |
| 2 | AAA Battery |
| 1 | User Manual |
Shipping details:
Please copy your tracking number to yunexpress Track & Trace Platform to get your shipping details: https://www.yuntrack.com/
Brinyte has Merchant Return Policy:
Please check here to get more Wannty&Return Policy details https://brinytestore.com/blogs/brinyte-light/warranty-return-policy